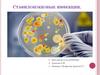
Стафилококковые инфекции

Similar presentations:
Диагностика стафилококковой инфекции
1. ОБЛАСТНОЕ ГОСУДАРСТВЕННОЕ АВТОНОМНОЕ ПРОФЕССИОНАЛЬНОЕ ОБРАЗОВАТЕЛЬНОЕ УЧРЕЖДЕНИЕ «СТАРООСКОЛЬСКИЙ МЕДИЦИНСКИЙ КОЛЛЕДЖ»
Методы лабораторной диагностики стафилококковой инфекциив лаборатории клинической микробиологии ОГБУЗ «Старооскольская
окружная больница Святителя Луки Крымского»
Выполнила студентка 320 группы
специальности 31.02.03
Лабораторная диагностика
Симакова Валерия Сергеевна
Научный руководитель
Устинова Ольга Вячеславовна
Старый Оскол - 2021 год
2.
АктуальностьСреди большого количества условно-патогенных возбудителей
лидируют кокки, к которым относятся и стафилококки. Стафилококки −
уникальные микроорганизмы: они могут вызывать более 100 различных
заболеваний, поражать любую ткань, любой орган, начиная от заболеваний
кожи и подкожной клетчатки до тяжелейшего сепсиса (заражения крови), в
том числе у новорожденных.
3.
Цель работыИзучение
методов
микробиологической
диагностики
стафилококковой инфекции в
лаборатории клинической
микробиологии ОГБУЗ «Старооскольская окружная больница
святителя Луки Крымского».
4.
Задачи− изучить учебно-методическую литературу, касающуюся как
самого заболевания, так и его диагностики;
−
оценить
методы
микробиологической
диагностики
стафилококковой инфекции, используемые в лаборатории
клинической микробиологии ОГБУЗ «Старооскольская окружная
больница святителя Луки Крымского»;
– проанализировать статистические данные высеваемости
патогенных стафилококков в ОГБУЗ «Старооскольская окружная
больница святителя Луки Крымского» за 2018-2020 гг.
5.
Объект исследования: стафилококковая инфекция.Предмет исследования: сравнение методов микробиологической диагностики стафилококковой инфекции.
Материалом исследования послужили годовые отчеты и
лабораторные журналы о высеваемости патогенных стафилококков за 2018-2020 года, предоставленные ЛКМ ОГБУЗ
«Старосокльская
окружная
больница
святителя
Луки
Крымского».
Методы исследования:
• научно-теоретический анализ литературы;
• сравнение методов лабораторной диагностики
стафилококковой инфекции;
• анализ статистических данных по данной проблеме.
6.
Стафилококковая инфекцияЭто сложный патологический процесс взаимодействия
стафилококка и организма человека с широким диапазоном
проявлений ‒ от бессимптомного носительства до тяжелой
интоксикации и развития гнойно-воспалительных очагов.
7. Лабораторная диагностика
стафилококковой инфекции8.
Микроскопический методМикроскопический метод имеет самостоятельное значение
лишь при асептической работе с материалами, которые у
здорового
человека
стерильны
(например,
кровь,
спинномозговая жидкость). Обнаружение стафилококков при
этом имеет самостоятельное диагностическое значение. В
остальных случаях микроскопический метод применяется как
предварительный, ориентировочный.
9.
Биологический методПринцип его сводится к скармливанию остатков пищи,
подозрительной
на
инфицированность
стафилококком,
выделенной культуры, промывных вод. Лучшей биологической
моделью при этом являются 1,5-2-месячные котята (для
исследования культуры) и взрослые кошки (при выявлении
энтеротоксина). При капельных стафилококковых инфекции их
этот метод не применяется.
10.
Бактериологический методПервый день исследования. Биоматериал засевают на
ЖСА (желточно-солевой агар), МСА (молочно-солевой агар) и
кровяной агар. Ставят в термостат при 37С на 24 часа.
11.
Второй день исследования. Изучение культуральныхсвойств:
• на желточно-солевом агаре патогенные стафилококки вокруг колонии образуется помутнение в виде радужного
(перламутрового)
венчика,
так
как
лецитовителаза
стафилококка расщепляет лецитин питательной среды;
• на молочно-солевом агаре − колонии по цвету желтые,
лимонно-желтые или белые;
• на кровяном агаре зоны гемолиза.
12.
Третий день исследования:1. Определяют чистоту выделенной культуры − окрашивают препарат по
Граму:
2. Определяют патогенные свойства:
а) с чистой культуры ставят реакцию плазмокоагуляции.
13.
б) посев на желточно-солевом агаре − учет лецитиназной активности(перламутрового венчика):
в) посев на мясопептонном агаре с 1 % маннитом. При положительном
результате реакции наблюдается пожелтение среды вокруг бляшки, если же
окрашена сама бляшка, то результат реакции отрицательный
14.
г) определение каталазы: на предметное стекло наносят каплю 3%перекиси водорода и растирают в ней выделенную культуру. В случае
положительной реакции образуются пузыри, исчезающие в течение
минуты:
д) определение фосфатазной активности. Появление интенсивного
желтого окрашивания вокруг посевов регистрируется как положительная
реакция:
15.
е) Определение ДНКазной активности.При оценке реакции на ДНКазу возможны следующие варианты:
− наличие четкой зоны просветления среды - положительная реакция;
− полное отсутствие зоны просветления – отрицательная реакция.
ж) посев на кровяном агаре − для выявления гемолитических свойств
16.
3. Фаготипирование − для выявления источника инфекции.4. Посев культуры на МПА − для определения культуральных свойств.
5.Посев культуры стафилококка сплошным газоном для определения
чувствительности к антибиотикам.
17.
Четвертый день исследования. Производят учет результатов иидентификация выделенной культуры:
1. Реакция плазмокоагуляции – положительна.
2. На желточно-солевом агаре − перламутровый венчик вокруг колонии.
3. Расщепление маннита в анаэробных условиях (изменение цвета
среды).
4. Определение каталазы − в случае положительной реакции
образуются пузыри, исчезающие в течение минуты.
5. Определение фосфатахной активности −появление интенсивного
желтого окрашивания вокруг посевов.
6. Определение ДНКазной активности − наличие четкой зоны
просветления среды.
7. На кровяном агаре вокруг колонии зона гемолиза;
8. Лизис бактерий в соответствующем квадрате с фагом;
9. Диффузное помутнение на мясопептонном бульоне;
10. Определение зоны задержки роста − учет чувствительности к
антибиотикам.
18.
Серологические методыВторое место по значимости занимают серологические
методы, поскольку взаимодействие антигена и антитела
характеризуется высокой степенью специфичности. К таким
методам можно отнести: реакцию пассивной гемагглютинации
(РПГА) и иммуноферментный анализ (ИФА).
19.
Экспресс-диагностика стафилококковНаряду с рассмотренными методами особое значение
приобретают методы экспресс-диагностики, которые позволяют
поставить микробиологический диагноз в течение короткого
промежутка времени. К числу экспресс-методов можно отнести
Микро-Ла-тест.
20.
Количество проб биоматериала доставляемого из отделений городаСтарый Оскол
Название
2016 год
2017 год
2018 год
577 проб
1050 проб
1367 проб
Гинекологическое отделение
533 пробы
516 проб
503 пробы
Отделение новорожденных
174 пробы
228 проб
176 проб
Отделение патологии новорожденных
354 пробы
223 пробы
282 пробы
Детская поликлиника
543 пробы
532 пробы
503 пробы
Взрослая поликлиника
113 проб
42 пробы
19 проб
Детское инфекционное отделение
348 проб
330 проб
355 проб
ЛОР отделение
109 проб
100 проб
98 проб
Детское соматическое отделение
341 проба
368 проб
513 проб
Детское хирургическое отделение
125проб
93 пробы
121 проба
Детское травматологическое отделение
4 пробы
1 проба
9 проб
Взрослое хирургическое отделение
32 пробы
15 проб
18 проб
Взрослое травматологическое отделение
22 пробы
25 проб
35 проб
Отделение реанимации и терапии
137 проб
81 проба
69 проб
Отделение патологии беременных
534 пробы
670 проб
815 проб
Урологическое отделение
35 проб
63 пробы
20 проб
Неврологическое отделение
Кардиологическое отделение
Гастроэнтерологическое отделение
Травмпункт
2 пробы
2 пробы
2 пробы
1 проба
5 проб
2 пробы
2 пробы
4 пробы
8 проб
2 пробы
7 проб
3 пробы
Женская консультация
21.
Частота высеваемости Staphylococcus из общего числа пробдоставленных в ЛКМ ОГБУЗ «Старооскольская окружная больница
святителя Луки Крымского» в 2018-2020 гг
22.
Частота высеваемости Staphylococcus из различногоклинического материала в 2020 году
23.
Видовой состав Staphylococcus24.
Высеваемость St. aureus по отделениям ОГБУЗ«Старооскольская окружная больница святителя Луки
Крымского»
25.
Высеваемость St. epidermidis по отделениям ОГБУЗ«Старооскольская окружная больница святителя Луки
Крымского»
26.
Высеваемость St. haemolyticus по отделениям ОГБУЗ«Старооскольская окружная больница святителя Луки
Крымского»
27.
Чувствительность микроорганизмов рода Staphylococcusaureus к антибактериальным препаратам
28. Выводы
На основе анализа исследовательской работы можносделать следующие выводы:
1. Основное место в диагностике стафилококковой
инфекции в настоящее время занимает микробиологическая
диагностика возбудителя.
2. Наиболее эффективным методом в диагностике
стафилококковой инфекции является бактериологический
метод (посев на дифференциальные питательные среды).
3. Частота высеваемости патогенных стафилококков из
биологического материала остается на стабильном высоком
уровне – 21,0-24,7%.
29. Заключение
Рассмотрев все методы лабораторной диагностики стафилококковой инфекции можносделать вывод, что их диагностическая ценность неравнозначна. Ведущим методом
микробиологической диагностики является бактериологический метод, который используют
почти при всех заболеваниях, несмотря на его недостатки: длительность исследования (от 4-5
дней), опасность (так как накапливается чистая культура возбудителя), сравнительную
дороговизну.
Второе место по значимости занимает серологический метод, поскольку взаимодействие
антигена и антитела характеризуется высокой степенью специфичности. Недостатком метода
является и то, что с его помощью нельзя точно идентифицировать возбудителя и определить
его антибиотикограмму. Но в то же время это совершенно безопасный, относительно
недорогой метод, позволяющий за короткое время поставить диагноз.
Биологический метод неэкономичен, негуманен, поэтому находит ограниченное
применение.
Достоинствами микроскопического метода являются простота, быстрота, экономичность.
Однако он находит ограниченное применение, так как может быть использован лишь при
наличии каких-либо морфологических или тинкториальных особенностей возбудителя и
достаточном его содержании в исследуемом материале. Данный метод является
ориентировочным.
Наряду с рассмотренными методами особое значение приобретают методы экспрессдиагностики, которые позволяют поставить микробиологический диагноз в течение короткого
промежутка времени с момента доставки исследуемого материала в лабораторию. К числу
экспресс-метода можно отнести Микро-Ла-тест.
30. Информационные ресурсы
1. Акопова, И.С. Видовой состав стафилококковой микрофлоры / И.С. Акопова, И.А.Новицкий, О.В. Перьянова. − СПб.: Аура, 2016. – 121с.
2. Бондаренко, В.М. Общий анализ представлений о патогенных и условно
патогенных бактериях / В.М. Бондаренко // Журнал микробиологии, эпидемиологии и
иммунологии. − М., 2015. − № 4. − С.20-26.
3.
Волков,
И.И.
Совершенствование
микробиологической
диагностики
стафилококковых инфекций и экологические аспекты, их возбудителей /И.И. Волков. −
СПб.: Эко-Мед, 2016. − 130с.
4. Гончарова, Г.И. Стафилококки / Г.И. Гончарова, В.Г. Дорофейчук, A.B. Смоленская.
− М.: Микрос, 2015. − 466с.
5. Дерябин, Д.Г. Стафилококки: экология и патогенность / Д.Г. Дерябин. −
Екатеринбург: УРО РАН, 2015. − 238с.
6. Дехнич, A.B. Staphylococcus aureus / А.В. Дехнич. − Смоленск: Профмед, 2014. −
122с.
7. Касымов, К.Т. Патогенные стафилококки / К.Т. Касымов. − М.: Лабораторное дело,
2016. – 303с.
8. Красильников, А.П. Устойчивость к антисептикам клинических штаммов
Staphylococcus / А.П. Красильников, А.А. Адарченко, О.П. Собешук // Журнал
микробиологии, эпидемиологии и иммунологии, 2014.− №7. − С.30-36.
9. Областной доклад «О состоянии санитарно-эпидемиологического благополучия
населения в Белгородской области в 2019 году». − Белгород, 2020. − 255с.































 medicine
medicine